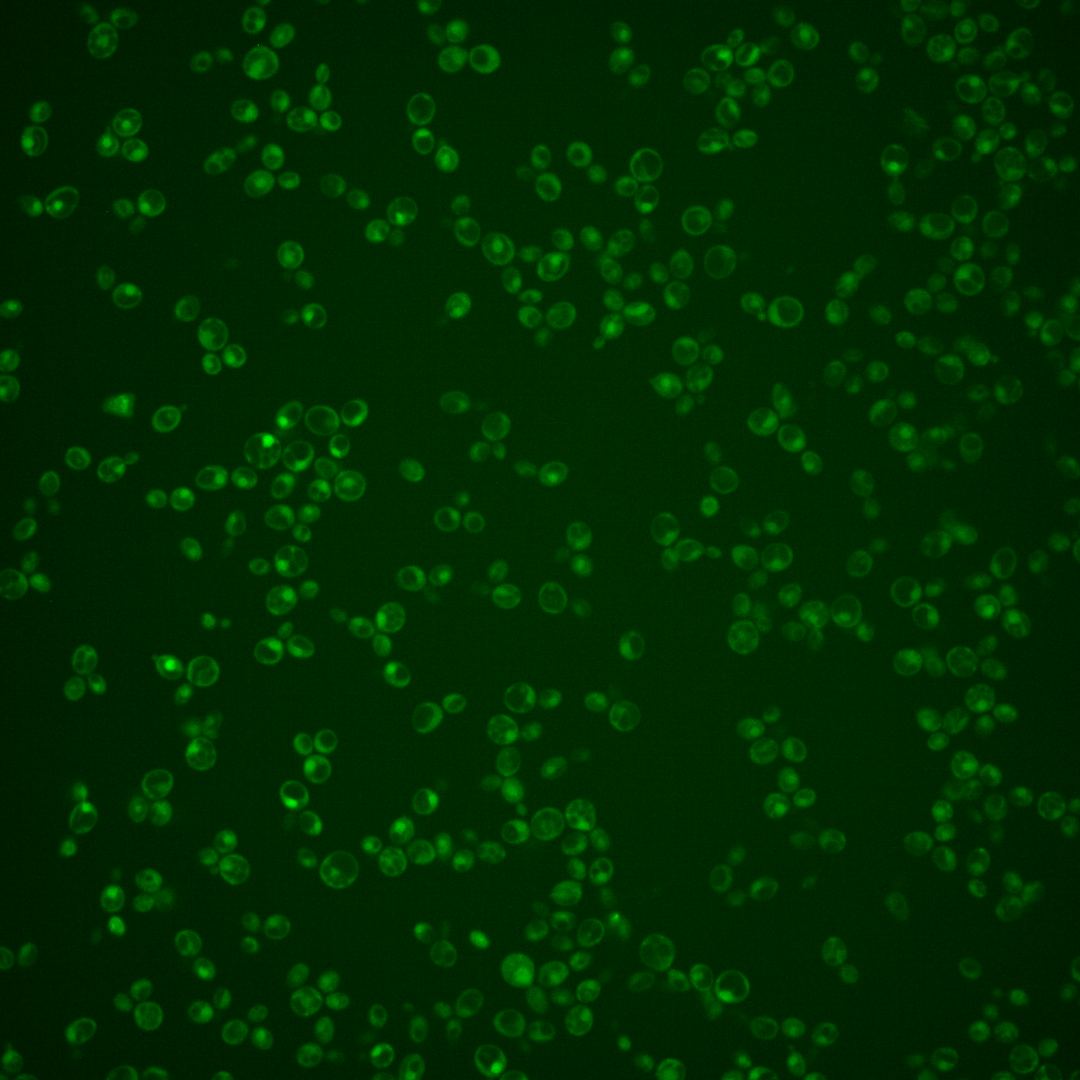
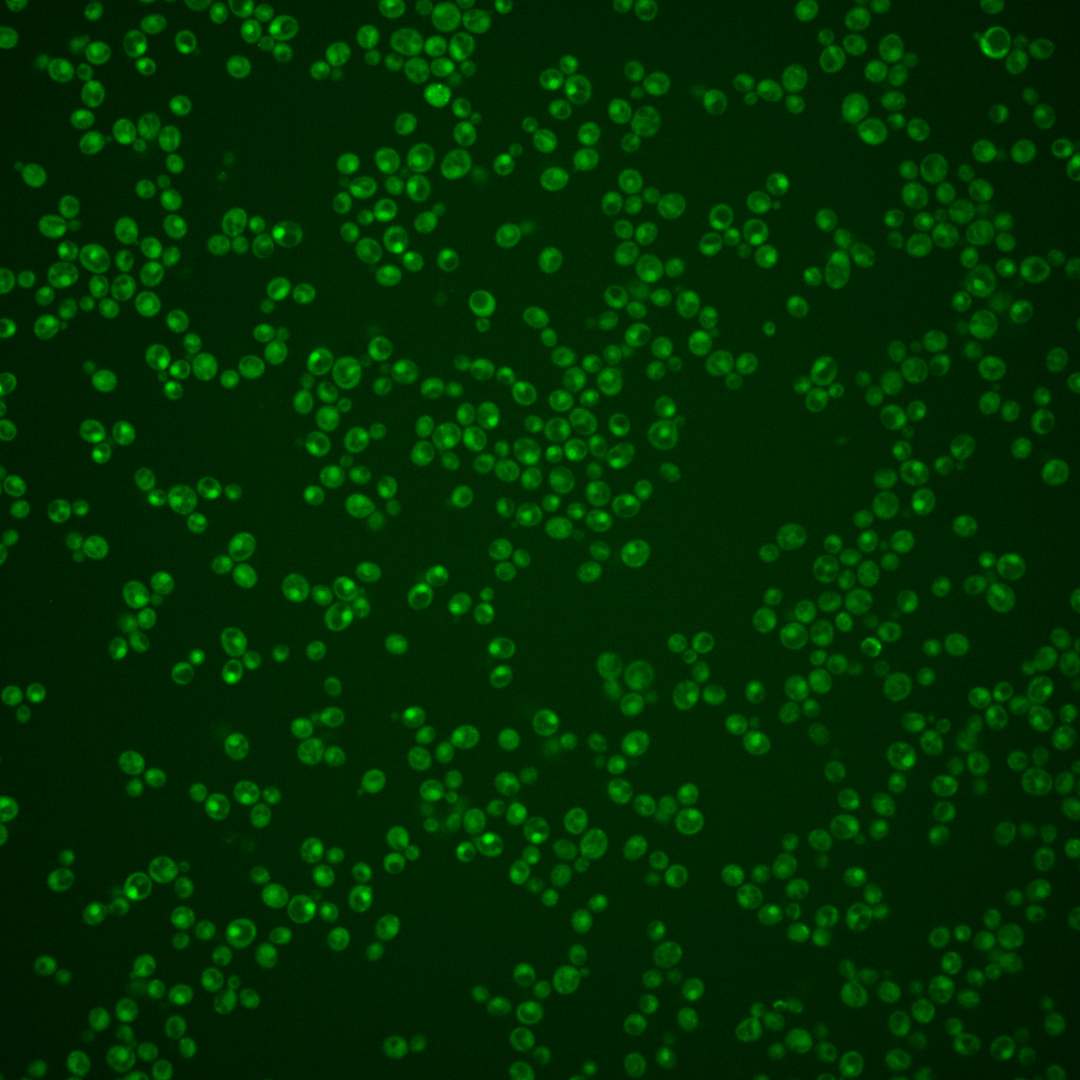
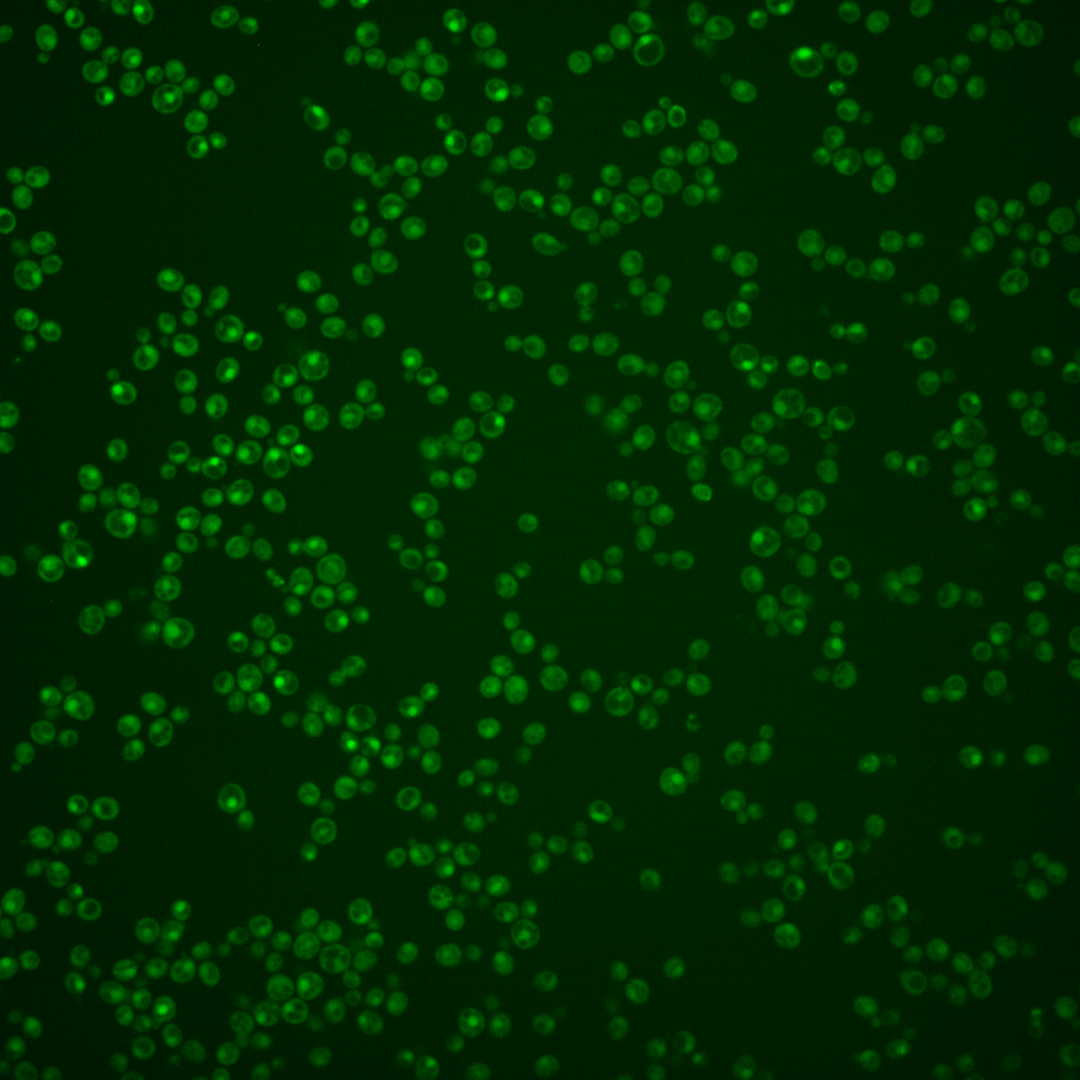
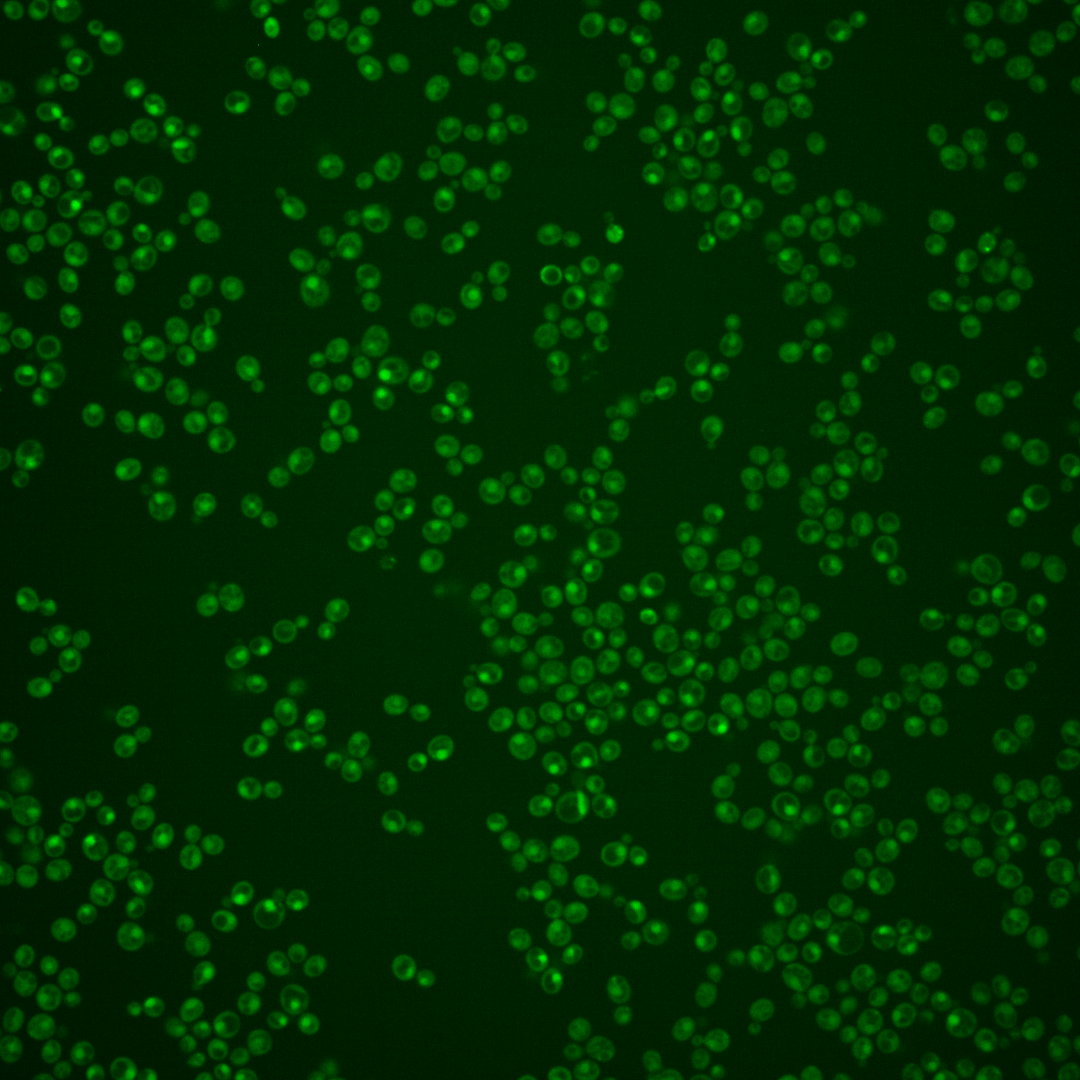
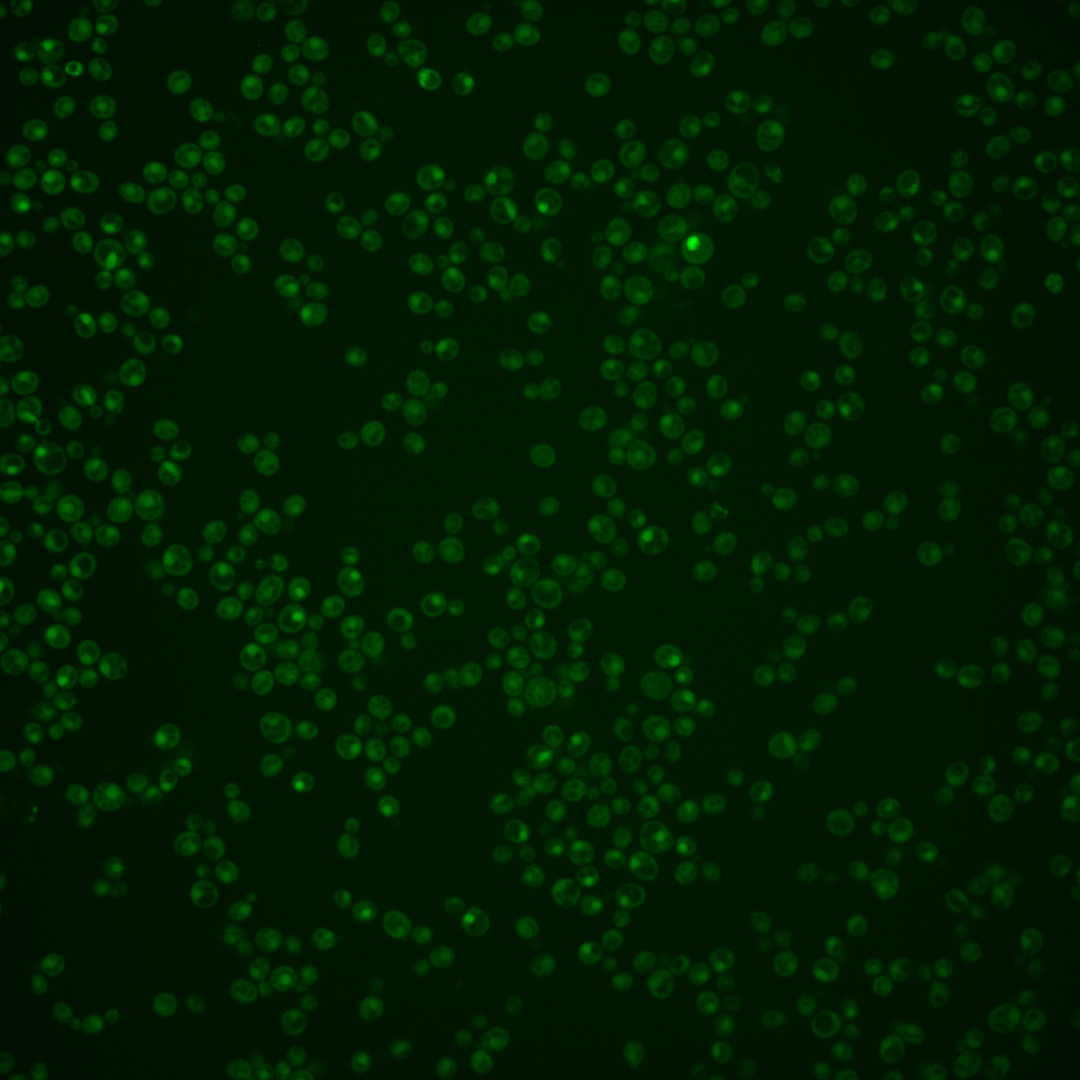

| ORF | |
|---|---|
| Human Ortholog | |
| Description | Putative protein of unknown function; green fluorescent protein (GFP)-fusion protein localizes to the cytoplasm and the nucleus; overexpression causes a cell cycle delay or arrest; YML053C is not an essential gene |
Micrographs




















































































Sub-cellular Localization
Yeast GFP Assignment
Protein Abundance
Localization Change
External localization resources
| ensLOC | DeepLoc | |||||||||||||||||||||||
|---|---|---|---|---|---|---|---|---|---|---|---|---|---|---|---|---|---|---|---|---|---|---|---|---|
| Localization | WT1 | WT2 | WT3 | RAP60 | RAP140 | RAP220 | RAP300 | RAP380 | RAP460 | RAP540 | RAP620 | RAP700 | HU80 | HU120 | HU160 | rpd3Δ_1 | rpd3Δ_2 | rpd3Δ_3 | WT1 | WT2 | WT3 | AF100 | AF140 | AF180 |
| Cortical Patches | 0 | 0 | 0 | 0 | 0 | 0 | 0 | – | 0 | 1 | 0 | 1 | 0 | 0 | 0 | 1 | 0 | 0 | 3 | 1 | 3 | 0 | 1 | 2 |
| Bud | 0 | 0 | 0 | 1 | 0 | 2 | 2 | – | 6 | 6 | 8 | 10 | 0 | 1 | 0 | 1 | 1 | 0 | 8 | 3 | 3 | 2 | 10 | 9 |
| Bud Neck | 1 | 0 | 4 | 2 | 1 | 1 | 3 | – | 4 | 5 | 3 | 5 | 0 | 0 | 0 | 1 | 1 | 0 | 3 | 2 | 2 | 1 | 2 | 7 |
| Bud Site | 0 | 0 | 0 | 0 | 0 | 0 | 0 | – | 0 | 0 | 2 | 3 | 0 | 0 | 0 | 0 | 0 | 0 | – | – | – | – | – | – |
| Cell Periphery | 0 | 0 | 0 | 1 | 2 | 1 | 2 | – | 0 | 3 | 2 | 3 | 1 | 0 | 0 | 0 | 1 | 1 | 0 | 0 | 0 | 0 | 0 | 0 |
| Cytoplasm | 222 | 149 | 203 | 232 | 335 | 319 | 534 | – | 337 | 378 | 335 | 448 | 90 | 164 | 265 | 103 | 73 | 94 | 211 | 127 | 176 | 78 | 190 | 195 |
| Endoplasmic Reticulum | 0 | 1 | 1 | 0 | 0 | 1 | 0 | – | 0 | 0 | 0 | 0 | 0 | 0 | 0 | 12 | 4 | 3 | 2 | 0 | 1 | 1 | 2 | 1 |
| Endosome | 10 | 0 | 4 | 3 | 12 | 2 | 15 | – | 4 | 4 | 4 | 7 | 15 | 6 | 7 | 10 | 3 | 2 | 9 | 3 | 2 | 0 | 1 | 2 |
| Golgi | 2 | 0 | 0 | 0 | 0 | 0 | 1 | – | 0 | 0 | 0 | 0 | 0 | 0 | 0 | 0 | 1 | 0 | 2 | 1 | 0 | 2 | 2 | 3 |
| Mitochondria | 16 | 24 | 4 | 18 | 8 | 59 | 60 | – | 145 | 133 | 211 | 229 | 0 | 0 | 0 | 3 | 5 | 8 | 6 | 7 | 10 | 1 | 6 | 6 |
| Nucleus | 53 | 11 | 16 | 19 | 9 | 10 | 11 | – | 10 | 23 | 13 | 16 | 22 | 4 | 2 | 39 | 24 | 26 | 125 | 48 | 59 | 14 | 10 | 6 |
| Nuclear Periphery | 1 | 0 | 0 | 0 | 0 | 0 | 0 | – | 0 | 1 | 2 | 4 | 0 | 0 | 0 | 0 | 0 | 0 | 1 | 0 | 0 | 0 | 0 | 0 |
| Nucleolus | 0 | 1 | 2 | 0 | 0 | 0 | 0 | – | 0 | 0 | 1 | 1 | 0 | 0 | 0 | 0 | 0 | 0 | 0 | 0 | 0 | 0 | 1 | 0 |
| Peroxisomes | 0 | 0 | 0 | 0 | 1 | 0 | 0 | – | 0 | 0 | 1 | 1 | 0 | 0 | 0 | 0 | 0 | 0 | 0 | 0 | 0 | 0 | 0 | 0 |
| SpindlePole | 0 | 0 | 1 | 1 | 5 | 2 | 18 | – | 5 | 5 | 5 | 11 | 0 | 0 | 0 | 0 | 0 | 0 | 13 | 8 | 8 | 0 | 4 | 9 |
| Vac/Vac Membrane | 135 | 50 | 42 | 29 | 57 | 8 | 36 | – | 22 | 16 | 15 | 20 | 51 | 33 | 23 | 66 | 52 | 52 | 72 | 36 | 52 | 13 | 23 | 10 |
| Unique Cell Count | 383 | 211 | 259 | 287 | 389 | 372 | 624 | 453 | 500 | 513 | 631 | 153 | 193 | 284 | 194 | 140 | 155 | 468 | 249 | 336 | 122 | 262 | 263 | |
| Labelled Cell Count | 440 | 236 | 277 | 306 | 430 | 405 | 682 | 533 | 575 | 602 | 759 | 179 | 208 | 297 | 236 | 165 | 186 | 468 | 249 | 336 | 122 | 262 | 263 | |
Yeast GFP Assignment
Protein Abundance
| Screen | WT1 | WT2 | WT3 | RAP60 | RAP140 | RAP220 | RAP300 | RAP380 | RAP460 | RAP540 | RAP620 | RAP700 | HU80 | HU120 | HU160 | rpd3Δ_1 | rpd3Δ_2 | rpd3Δ_3 | AF100 | AF140 | AF180 |
|---|---|---|---|---|---|---|---|---|---|---|---|---|---|---|---|---|---|---|---|---|---|
| Mean Cell GFP Intensity (1e-4) | 4.4 | 4.1 | 5.4 | 4.9 | 5.5 | 3.9 | 4.4 | – | 3.8 | 3.9 | 3.7 | 3.8 | 6.0 | 5.3 | 5.3 | 5.7 | 6.0 | 6.0 | 4.8 | 4.8 | 5.2 |
| Std Deviation (1e-4) | 0.7 | 0.8 | 1.7 | 2.0 | 1.8 | 2.3 | 1.7 | – | 1.3 | 1.2 | 1.3 | 1.1 | 3.1 | 1.7 | 1.6 | 1.0 | 1.0 | 1.0 | 1.6 | 1.8 | 2.7 |
| Intensity Change (Log2) | – | – | – | -0.13 | 0.03 | -0.45 | -0.28 | – | -0.52 | -0.45 | -0.53 | -0.51 | 0.17 | -0.02 | -0.04 | 0.09 | 0.15 | 0.15 | -0.17 | -0.16 | -0.06 |
Localization Change
| Localization | RAP60 | RAP140 | RAP220 | RAP300 | RAP380 | RAP460 | RAP540 | RAP620 | RAP700 | HU80 | HU120 | HU160 | rpd3Δ_1 | rpd3Δ_2 | rpd3Δ_3 |
|---|---|---|---|---|---|---|---|---|---|---|---|---|---|---|---|
| Actin | – | – | – | – | – | – | – | – | – | – | – | – | – | – | – |
| Bud | – | – | – | – | – | – | – | – | – | – | – | – | 0 | 0 | 0 |
| Bud Neck | – | – | – | – | – | – | – | – | – | – | – | – | 0 | 0 | 0 |
| Bud Site | – | – | – | – | – | – | – | – | – | – | – | – | 0 | 0 | 0 |
| Cell Periphery | – | – | – | – | – | – | – | – | – | – | – | – | 0 | 0 | 0 |
| Cyto | – | – | – | – | – | – | – | – | – | – | – | – | – | – | – |
| Endoplasmic Reticulum | – | – | – | – | – | – | – | – | – | – | – | – | 0 | 0 | 0 |
| Endosome | – | – | – | – | – | – | – | – | – | – | – | – | 0 | 0 | 0 |
| Golgi | – | – | – | – | – | – | – | – | – | – | – | – | 0 | 0 | 0 |
| Mitochondria | – | – | – | – | – | – | – | – | – | – | – | – | 0 | 0 | 0 |
| Nuclear Periphery | – | – | – | – | – | – | – | – | – | – | – | – | 0 | 0 | 0 |
| Nuc | – | – | – | – | – | – | – | – | – | – | – | – | – | – | – |
| Nucleolus | – | – | – | – | – | – | – | – | – | – | – | – | 0 | 0 | 0 |
| Peroxisomes | – | – | – | – | – | – | – | – | – | – | – | – | 0 | 0 | 0 |
| SpindlePole | – | – | – | – | – | – | – | – | – | – | – | – | 0 | 0 | 0 |
| Vac | – | – | – | – | – | – | – | – | – | – | – | – | – | – | – |
| Cortical Patches | – | – | – | – | – | – | – | – | – | – | – | – | 0 | 0 | 0 |
| Cytoplasm | – | – | – | – | – | – | – | – | – | – | – | – | 0 | 0 | 0 |
| Nucleus | – | – | – | – | – | – | – | – | – | – | – | – | 0 | 0 | 0 |
| Vacuole | – | – | – | – | – | – | – | – | – | – | – | – | 4.4 | 4.7 | 4.1 |
External localization resources
Images






























Protein Concentration and Protein Localization Data
| R1 | R2 | R3 | ||||||||||||||||
|---|---|---|---|---|---|---|---|---|---|---|---|---|---|---|---|---|---|---|
| G1 Pre-START | G1 Post-START | S/G2 | Metaphase | Anaphase | Telophase | G1 Pre-START | G1 Post-START | S/G2 | Metaphase | Anaphase | Telophase | G1 Pre-START | G1 Post-START | S/G2 | Metaphase | Anaphase | Telophase | |
| Concentration | -0.4444 | -0.1311 | -0.3129 | -0.4552 | -0.6358 | -0.4104 | 1.2629 | 1.24 | 0.9036 | 1.4465 | 0.8475 | 0.8908 | 2.1197 | 3.0868 | 2.5897 | 2.3727 | 2.1222 | 2.5258 |
| Actin | 0.012 | 0.0005 | 0.0085 | 0.0002 | 0.0173 | 0.005 | 0.0342 | 0.0004 | 0.0091 | 0.0217 | 0.0137 | 0.0027 | 0.0089 | 0.0002 | 0.0004 | 0.0006 | 0.0136 | 0.0022 |
| Bud | 0.001 | 0.0017 | 0.0003 | 0 | 0.0003 | 0.0002 | 0.002 | 0.0007 | 0.0006 | 0.0005 | 0.0002 | 0.0008 | 0.0003 | 0.0001 | 0.0001 | 0.0001 | 0.0003 | 0.0001 |
| Bud Neck | 0.0041 | 0.0009 | 0.0009 | 0.0004 | 0.0051 | 0.0034 | 0.0047 | 0.0025 | 0.001 | 0.0467 | 0.0009 | 0.008 | 0.0054 | 0.0006 | 0.0004 | 0.0009 | 0.0009 | 0.0029 |
| Bud Periphery | 0.0016 | 0.0005 | 0.0002 | 0 | 0.0004 | 0.0002 | 0.0028 | 0.0006 | 0.0004 | 0.0007 | 0.0004 | 0.0015 | 0.0002 | 0.0001 | 0.0001 | 0 | 0.0003 | 0.0001 |
| Bud Site | 0.0128 | 0.0046 | 0.0025 | 0.0004 | 0.0032 | 0.0003 | 0.0067 | 0.0055 | 0.0019 | 0.0019 | 0.0009 | 0.0011 | 0.0044 | 0.0013 | 0.0004 | 0.0003 | 0.0005 | 0.0002 |
| Cell Periphery | 0.0008 | 0.0001 | 0.0001 | 0 | 0.0001 | 0 | 0.0004 | 0.0001 | 0.0001 | 0.0002 | 0.0002 | 0.0001 | 0.0002 | 0.0001 | 0.0001 | 0 | 0 | 0 |
| Cytoplasm | 0.2868 | 0.2725 | 0.1746 | 0.1514 | 0.2058 | 0.2032 | 0.2918 | 0.3679 | 0.239 | 0.1173 | 0.2015 | 0.2895 | 0.4091 | 0.3211 | 0.2267 | 0.3397 | 0.307 | 0.3514 |
| Cytoplasmic Foci | 0.0292 | 0.0067 | 0.0083 | 0.0039 | 0.023 | 0.0079 | 0.0378 | 0.0054 | 0.0046 | 0.0175 | 0.0036 | 0.0084 | 0.0111 | 0.0045 | 0.0025 | 0.0029 | 0.0144 | 0.0046 |
| Eisosomes | 0.0004 | 0.0001 | 0.0001 | 0 | 0.0002 | 0.0001 | 0.0003 | 0 | 0 | 0.0001 | 0.002 | 0 | 0.0025 | 0 | 0.0001 | 0.0001 | 0 | 0.0001 |
| Endoplasmic Reticulum | 0.0128 | 0.0096 | 0.0052 | 0.0021 | 0.0065 | 0.0031 | 0.0116 | 0.0057 | 0.0031 | 0.0018 | 0.0028 | 0.0034 | 0.0067 | 0.0044 | 0.0029 | 0.0032 | 0.0022 | 0.0032 |
| Endosome | 0.0621 | 0.0093 | 0.0184 | 0.0029 | 0.022 | 0.0134 | 0.0574 | 0.005 | 0.0066 | 0.0183 | 0.0046 | 0.0127 | 0.0129 | 0.004 | 0.0021 | 0.003 | 0.0052 | 0.0044 |
| Golgi | 0.0139 | 0.0002 | 0.0055 | 0.0001 | 0.0136 | 0.0047 | 0.024 | 0.0001 | 0.0025 | 0.0095 | 0.0015 | 0.0037 | 0.001 | 0.0001 | 0.0001 | 0.0001 | 0.0029 | 0.0006 |
| Lipid Particles | 0.0159 | 0.0009 | 0.002 | 0.0003 | 0.0226 | 0.0097 | 0.0318 | 0.0004 | 0.0006 | 0.0104 | 0.0016 | 0.0026 | 0.0016 | 0.0003 | 0.0002 | 0.0004 | 0.004 | 0.0006 |
| Mitochondria | 0.0297 | 0.0008 | 0.0059 | 0.0004 | 0.0305 | 0.0019 | 0.0167 | 0.0005 | 0.0029 | 0.0025 | 0.0189 | 0.007 | 0.002 | 0.0005 | 0.001 | 0.0008 | 0.0024 | 0.0008 |
| None | 0.0903 | 0.2279 | 0.1379 | 0.1579 | 0.0786 | 0.1345 | 0.1255 | 0.1994 | 0.1288 | 0.0512 | 0.1103 | 0.0972 | 0.218 | 0.1949 | 0.2118 | 0.2084 | 0.1771 | 0.1874 |
| Nuclear Periphery | 0.0437 | 0.0462 | 0.038 | 0.0102 | 0.0426 | 0.0216 | 0.0363 | 0.0192 | 0.0199 | 0.0083 | 0.0146 | 0.0229 | 0.0156 | 0.0114 | 0.0121 | 0.0087 | 0.0133 | 0.0076 |
| Nucleolus | 0.0037 | 0.0027 | 0.0019 | 0.002 | 0.0015 | 0.0027 | 0.0026 | 0.0017 | 0.0016 | 0.003 | 0.0027 | 0.0035 | 0.0023 | 0.0017 | 0.0015 | 0.0011 | 0.0015 | 0.0021 |
| Nucleus | 0.3088 | 0.3796 | 0.5482 | 0.6033 | 0.4665 | 0.5564 | 0.249 | 0.3548 | 0.5516 | 0.6088 | 0.588 | 0.5016 | 0.2652 | 0.4365 | 0.5261 | 0.4177 | 0.3945 | 0.4052 |
| Peroxisomes | 0.0108 | 0.0002 | 0.0086 | 0.0001 | 0.0092 | 0.0022 | 0.0329 | 0.0001 | 0.0027 | 0.0344 | 0.0012 | 0.0011 | 0.002 | 0.0001 | 0.0001 | 0.0001 | 0.0171 | 0.0002 |
| Punctate Nuclear | 0.0365 | 0.0303 | 0.0295 | 0.0634 | 0.0484 | 0.0271 | 0.0172 | 0.0263 | 0.02 | 0.0432 | 0.0286 | 0.0271 | 0.0275 | 0.0149 | 0.0099 | 0.0102 | 0.0407 | 0.0244 |
| Vacuole | 0.0166 | 0.0039 | 0.0026 | 0.0009 | 0.0016 | 0.0017 | 0.0095 | 0.0032 | 0.0025 | 0.0015 | 0.0013 | 0.0036 | 0.0027 | 0.0028 | 0.0012 | 0.0012 | 0.0018 | 0.0015 |
| Vacuole Periphery | 0.0063 | 0.0009 | 0.0009 | 0.0002 | 0.001 | 0.0006 | 0.0046 | 0.0006 | 0.0006 | 0.0004 | 0.0005 | 0.0013 | 0.0005 | 0.0003 | 0.0002 | 0.0002 | 0.0003 | 0.0003 |
Sequencing Data
| R1 | R2 | |||||||||
|---|---|---|---|---|---|---|---|---|---|---|
| G1 Post-START | S/G2 | Metaphase | Anaphase | Telophase | G1 Post-START | S/G2 | Metaphase | Anaphase | Telophase | |
| Gene Expression | 14.6775 | 9.2617 | 16.0361 | 22.1067 | 13.433 | 10.3549 | 18.7291 | 18.9613 | 15.3963 | 23.5935 |
| Translational Efficiency | 2.7273 | 3.8637 | 1.5754 | 0.827 | 2.9416 | 4.1016 | 2.3321 | 2.1294 | 2.5849 | 2.5304 |
Hit Data
| Dataset | Hit |
|---|---|
| Protein Concentration | ✘ |
| Protein Localization | ✘ |
| Gene Expression | ✘ |
| Translational Efficiency | ✘ |
Endocytosis
| Temp | Actin Patch (Sac6-tdTomato) | Cortical Patch (Sla1-GFP) | Late Endosome (Snf7-GFP) | Vacuole (Vph1-GFP) |
|---|---|---|---|---|
| 37℃ | ||||
| RT |
Cell Cycle Omics
CYCLoPs (Yml053c-GFP)
| Gene / Allele | Actin Patch (Sac6-tdTomato) | Cortical Patch (Sla1-GFP) | Late Endosome (Snf7-GFP) | Vacuole (Sac6-tdTomato) |
|---|
| Gene | Images |
|---|
| Gene | Images |
|---|
Images are not yet available
Images are not yet available